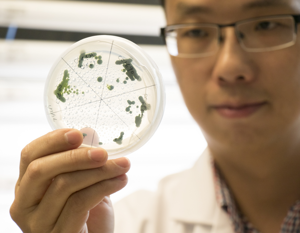

-
 Environmental initiatives
Environmental initiativesDigitalisation can help biggest industrial companies reduce carbon footprint, GSMA says
03 March 2023Mobile and digital technology can help cut about 40 per cent of the required carbon dioxide emissions within the industrial world's top emitters in the next 10 years, London-based industry body GSMA has said. https://www.thenationalnews.com/business/technology/2023/03/02/digitalisation-can-help-biggest-industrial-companies-reduce-carbon-footprint-gsma-says/
-
 Environmental initiatives
Environmental initiativesKeto diet has highest carbon footprint and lowest nutritional value
03 March 2023Tulane University has compared popular diets analysing their nutritional quality and environmental impact, revealing that the keto diet ranks the worst https://www.openaccessgovernment.org/keto-diet-highest-carbon-footprint-lowest-nutritional-value/154073/
-
 Environmental initiatives
Environmental initiativesHow JFK’s New Microgrid Will Reduce Emissions and Boost Resilience
03 March 2023Schneider Electric and its joint venture AlphaStruxure are illuminating a new pathway to decarbonizing air transportation at the New Terminal One (NTO) at John F. Kennedy International Airport. https://www.greenbiz.com/webcast/how-jfks-new-microgrid-will-reduce-emissions-and-boost-resilience
-
 Environmental initiatives
Environmental initiativesWhat lies ahead for Canada's economy as it seeks to reduce carbon emissions
03 March 2023In 2021, Canada’s carbon emissions grew, but not as fast as the economy, according to Sawyer, who added that carbon intensity here — a ratio of emissions and GDP activity — declined by about two per cent. https://financialpost.com/commodities/energy/canada-economy-reduce-carbon-emissions
-
 Environmental initiatives
Environmental initiativesTop Tips to reduce your dishwashing Carbon footprint
03 March 2023Data from the World Meteorological Organization (WMO) suggests that in 2022, global greenhouse emissions increased. https://www.euractiv.com/section/energy-environment/opinion/top-tips-to-reduce-your-dishwashing-carbon-footprint/
-
 Environmental initiatives
Environmental initiativesEPA launches first funding phase of $5B carbon reduction program for states, cities, tribes
03 March 2023New Jersey expects to use the funding to find ways to speed greenhouse gas reduction plans, state commissioner said on February 28, 2023. https://www.utilitydive.com/news/epa-funding-carbon-reduction-program-states-tribes/643833/
-
 Environmental initiatives
Environmental initiativesRising global emissions reveal a troubling ‘say–do’ gap
03 March 2023Earth Index analysis of new IEA data reveals that no countries are doing enough to reach 2030 emissions targets https://www.corporateknights.com/category-climate/rising-global-greenhouse-gas-emissions-reveal-a-troubling-say-do-gap/
-
 Environmental initiatives
Environmental initiativesResearch identifies best and worst performing cities in reducing air pollution
03 March 2023A new study has compared PM2.5 levels from 2019 to 2022 levels in 480 cities across the world to identify which ones are making the best progress in reducing air pollution and which are failing miserably https://airqualitynews.com/2023/03/02/research-identifies-best-and-worst-performing-cities-in-reducing-air-pollution/
-
 Environmental initiatives
Environmental initiativesNew report warns that we must reduce pollution to fight superbugs
03 March 2023The “Bracing for Superbugs” report warns us that climate change and pollution are contributing to the rise of bacteria that are resistant to antibiotics. https://www.lifegate.com/reduce-pollution-fight-superbugs
-
 Environmental initiatives
Environmental initiativesEco-Products Earns Industry First for Compostable Packaging with No-Added PFAS
02 March 2023Eco-Products® announced on March 1, 2023 that one of its Vanguard® clamshells has earned CMA-W approval from the Compost Manufacturing Alliance (CMA), making it the first molded fiber item made with no-added PFAS to be approved by CMA. https://www.prnewswire.com/news-releases/eco-products-earns-industry-first-for-compostable-packaging-with-no-added-pfas-301759035.html
-
 Environmental initiatives
Environmental initiativesEnvironmental auditors approve green labels for products linked to deforestation and authoritarian regimes
02 March 2023A new ICIJ-led cross-border investigation exposes how a lightly regulated sustainability industry overlooks forest destruction and human rights violations when granting environmental certifications. https://www.icij.org/investigations/deforestation-inc/auditors-green-labels-sustainability-environmental-harm/
-
 Environmental initiatives
Environmental initiativesPurchase costs of zero emission in the united states to meet the future phase 3 GHG standards
02 March 2023This study provides updated data on the upfront cost of zero-emission trucks. The assessment provides cost estimates up to 2040 for heavy-duty truck segments in the United States relevant to the upcoming Phase 3 greenhouse gas standards. https://theicct.org/publication/cost-zero-emission-trucks-us-phase-3-mar23/
-
 Environmental initiatives
Environmental initiativesMoon-dust shield could help fight climate change on Earth
02 March 2023Astronomers are exploring solutions to mitigate climate change, one of humanity's biggest challenges, by using some tiny players — dust particles. https://www.space.com/moon-dust-shield-earth-fight-climate-change
-
 Environmental initiatives
Environmental initiativesPorts reduce emissions amid deadlines and calls for more
02 March 2023The port complex encompasses so many things — trucks, ships, rail. A few of these elements are up against some big compliance deadlines, all to address pollution. https://spectrumnews1.com/ca/la-west/environment/2023/03/02/ports-reduce-emissions-amid-deadlines---calls-for-more
-
 Environmental initiatives
Environmental initiativesWhole Foods lags in reducing plastic pollution, report says
02 March 2023Customers who shop at Whole Foods are getting their groceries with a side order of plastic, a new report has found. https://thehill.com/policy/equilibrium-sustainability/3880897-whole-foods-lags-in-reducing-plastic-pollution-report-says/
-
 Lifestyle
LifestyleCan children make parents adopt more sustainable lifestyles? What is the role of New Education Policy?
02 March 2023Can our schools and the New Education Policy (NEP) somehow help us out of this predicament? What is the role teachers and their students can play in educating the households, communities and societies about the climate crisis? https://timesofindia.indiatimes.com/blogs/voices/can-children-make-parents-adopt-more-sustainable-lifestyles-what-is-the-role-of-new-education-policy/
-
 Living
LivingCouple sought to live and work on tiny off-grid Scottish island
02 March 2023The island is completely off-grid, has no shops or pub and is accessible only by boat, with the new arrivals to live alongside just two other people and a trickle of guests who head there for holidays. https://www.scotsman.com/heritage-and-retro/heritage/couple-sought-to-live-and-work-on-tiny-off-grid-scottish-island-4044518
-
 Environmental initiatives
Environmental initiativesThe Clorox Company Named Barron's Most Sustainable U.S. Company
02 March 2023The Clorox Company has earned the top ranking on Barron's 2023 100 Most Sustainable Companies list — its second time in the top five and fifth consecutive year in the top 25 since the rankings were first released in 2018. Clorox was selected for its continued efforts around sustainability, diversity and transparency. https://www.prnewswire.com/news-releases/the-clorox-company-named-barrons-most-sustainable-us-company-301761724.html
-
 Environmental initiatives
Environmental initiativesLet Oscar the Grouch teach you about sustainable aviation fuel
02 March 2023United Airlines is helping to educate consumers on fuel and sustainability, thanks to a new partnership with Oscar the Grouch, aviation and trash educator extraordinaire. https://www.timeout.com/usa/news/let-oscar-the-grouch-teach-you-about-sustainable-aviation-fuel-030323
-
 Mobility
MobilityAll those tiny homes made from shipping containers aren’t as sustainable as you think. Here’s why
01 March 2023Shipping containers are beloved for their aesthetic appeal and supposed sustainability. But the reality is a bit more complicated. https://www.fastcompany.com/90855327/all-those-tiny-homes-made-from-shipping-containers-arent-as-sustainable-as-you-think-heres-why
-
 Environmental initiatives
Environmental initiativesEPA to award $250 million in IRA funds to reduce climate pollution
01 March 2023The Biden Administration will make $250 million in grants available to develop strategies to cut climate pollution, the Environmental Protection Agency announced on March 1, 2023. https://thehill.com/policy/energy-environment/3878023-epa-to-award-250-million-in-ira-funds-to-reduce-climate-pollution/
-
 Environmental initiatives
Environmental initiativesWhat lies ahead for Canada's economy as it seeks to reduce carbon emissions
01 March 2023Fossil fuels have sometimes been described as the lifeblood of our economy: They power cars and various modes of transportation, electricity and so much more. https://financialpost.com/commodities/energy/canada-economy-reduce-carbon-emissions
-
 Environmental initiatives
Environmental initiativesDFW to get more federal money to reduce emissions
01 March 2023DFW Airport has been awarded another $35 million from the federal infrastructure bill to go toward the airport's goal of net-zero carbon emissions by 2030. https://www.axios.com/local/dallas/2023/02/28/dfw-federal-funding-reduce-emissions
-
 Mobility
MobilityDigital technologies can reduce emissions
01 March 2023The impacts of climate change are becoming more visible daily, putting pressure on nations to fulfil their commitments towards reducing carbon emissions. It is estimated that we need up to a 55% reduction in CO2 emissions to keep the goals of the Paris Agreement on track. https://www.dailypioneer.com/2023/columnists/digital-technologies-can-reduce-emissions.html
-
 Environmental initiatives
Environmental initiativesOakville Transit unveils first zero-emission battery electric buses
01 March 2023Oakville celebrates the arrival of its first batch of zero-emission battery electric buses, marking a significant step towards its commitment to reduce greenhouse gas emissions and implement sustainable initiatives in public transit. https://www.intelligenttransport.com/transport-news/144187/oakville-transit-unveils-first-zero-emission-battery-electric-buses/
-
 Environmental initiatives
Environmental initiativesZero-emission trains built in Utah promise a cleaner future
01 March 2023With concerns about air quality, increased gas prices and growing traffic, the world needs alternative transport modes. The desire to responsibly use the earth's natural resources, show respect for the environment and deliberately grow cities adds to the challenge to develop viable options. https://www.ksl.com/article/50582124/zero-emission-trains-built-in-utah-promise-a-cleaner-future
-
 Companies
CompaniesAET and PTLCL Sign MOU for Zero-emission Aframax
01 March 2023Tanker operator AET announced it has signed a memorandum of understanding (MOU) with Malaysia's PETCO Trading Labuan Company Ltd (PTLCL) to explore a potential collaboration to deploy a future zero-emission Aframax tanker powered by green ammonia. https://www.marinelink.com/news/aet-ptlcl-sign-mou-zeroemission-aframax-503263
-
 Companies
CompaniesThe New York Times Company Announces Pledge for Net Zero Carbon Emissions by 2030
01 March 2023The New York Times Company today announced that it has set a goal to achieve net zero emissions (Scope 1 and Scope 2) across its operations by year-end 2030. https://www.nytco.com/press/the-new-york-times-company-announces-pledge-for-net-zero-carbon-emissions-by-2030/
-
 People
PeopleWe need to act now to reach net zero emission by 2070: Ashok Singhal
01 March 2023Assam Urban Affairs and Irrigation Minister, Ashok Singhal, said on March 1 that human-made carbon emission needs to fall and that we need to work towards it from today itself to reach net zero emission by 2070. https://themeghalayan.com/we-need-to-act-now-to-reach-net-zero-emission-by-2070-ashok-singhal/
-
 Companies
CompaniesNeste introduces new sustainable lubricants product line
28 February 2023The company unveiled its latest ReNew family of lubricants created with renewable or re-refined base oils to reduce dependence on crude oil based products. https://www.petrolplaza.com/news/32179
-
 Companies
CompaniesClean Beauty Showcase Introduces U.S. Organic, Sustainable Products
28 February 2023Twenty-five top local distributors specializing in clean beauty products participated in the Greater China Virtual Clean Beauty Showcase, a business match-making event organized by the U.S. Commercial Service in Hong Kong and Macau on February 23, 2023. https://hk.usconsulate.gov/pr-2023022701/
-
 Environmental initiatives
Environmental initiativesAET and Petronas unit in talks over zero-emission ammonia-fueled Aframax
28 February 2023AET, the petroleum arm of MISC Group, has signed a memorandum of understanding (MoU) with PETCO Trading Labuan Company Ltd (PTLCL), an indirect wholly-owned unit of Petronas, to explore a potential collaboration for deploying a future zero-emission ammonia-powered Aframax. https://www.offshore-energy.biz/aet-and-petronas-unit-in-talks-over-zero-emission-ammonia-fueled-aframax/
-
 Environmental initiatives
Environmental initiativesSign Up for the 2023 Adopt-A-Beach Coastwide Spring Cleanup
28 February 2023On February 27, 2023 Texas General Land Office Commissioner Dawn Buckingham, M.D. reminds all interested volunteers to sign up for the 2023 Texas Adopt-A-Beach Coastwide Spring Cleanup on Saturday, April 22nd at 23 locations across the Texas coast, from Port Arthur to Boca Chica Beach. https://thekatynews.com/2023/02/27/sign-up-for-the-2023-adopt-a-beach-coastwide-spring-cleanup/
-
 Environmental initiatives
Environmental initiativesJet fuel from the air? How DOD contract aims to experiment with sustainable aviation fuel
28 February 2023Sustainable aviation fuel startup Air Company announced a $65 million deal on February 28, 2023 with the Department of Defense. https://www.usatoday.com/story/travel/airline-news/2023/02/28/experimental-aviation-fuel-air-force/11332701002/
-
 Environmental initiatives
Environmental initiativesAnother study says efforts to curb plastic waste will not make its goal
28 February 2023A new study from Back to Blue, an initiative of Economist Impact and The Nippon Foundation, says current United Nations efforts to halt the growth in plastic consumption and to "bend the curve" on plastics use will not achieve its goal by 2050. https://www.plasticsnews.com/news/another-study-says-efforts-curb-plastic-waste-will-not-make-its-goal
-
 Environmental initiatives
Environmental initiativesPolice and first responders to get three-wheel electric motorcycles
28 February 2023British automotive companies White Motorcycle Concepts and Mahle Powertrain are partnering to develop a fully electric three-wheeled motorcycle designed specifically for police and emergency first responders. https://thedriven.io/2023/02/27/police-and-first-responders-to-get-three-wheel-electric-motorcycles/
-
 Environmental initiatives
Environmental initiativesHow packaging companies are helping customers save money
28 February 2023In a world characterized by supply chain disruptions, spiraling inflation rates and increasing pressure for sustainability, just about every segment of the produce packaging industry seems to be taking steps to fill orders on time, keep costs under control and offer products that are environmentally friendly. https://www.thepacker.com/news/industry/how-packaging-companies-are-helping-customers-save-money
-
 Environmental initiatives
Environmental initiativesOcean plastic: How tech is being used to clean up waste problem
28 February 2023Trying to solve the world's ocean plastic pollution problem has been a "long and painful journey" for Dutch entrepreneur Boyan Slat. https://www.bbc.com/news/technology-64744926
-
 Environmental initiatives
Environmental initiativesJustice Department wants manufacturing plant in 'Cancer Alley' to reduce emissions
28 February 2023The Department of Justice is seeking to compel a chemical manufacturing plant to curb its emissions in a region where the estimated cancer risk is among the highest in the United States. https://www.nbcnews.com/news/us-news/justice-department-to-compel-denka-plant-reduce-emissions-rcna72685
-
 Environmental initiatives
Environmental initiativesScientists Boost The Efficiency of a Cheap And Promising Solar Panel Material by 250%
27 February 2023Cheaper to produce and better at absorbing higher energy forms of light, perovskite materials have the potential to replace silicon in solar panel technology https://www.sciencealert.com/scientists-boost-the-efficiency-of-a-cheap-and-promising-solar-panel-material-by-250
-
 Environmental initiatives
Environmental initiativesPlastic consumption of G20 nations set to double despite measures to cut single-use products
27 February 2023Plastic consumption is projected to double in the world’s 20 biggest economies by 2050, new research has found. https://news.yahoo.com/plastic-consumption-g20-nations-set-113516071.html
-
 Environmental initiatives
Environmental initiativesWoodside accused of not taking carbon emission responsibilities seriously in new climate report
27 February 2023Climate action groups are warning some of the nation's biggest emitters face growing increasingly isolated from shareholders and industry groups if they do not act to reduce their carbon output. https://www.abc.net.au/news/2023-02-28/climate-groups-criticise-woodside-over-climate-report/102028674
-
Environmental initiatives
Environmental initiativesResearchers pursue green technology to capture carbon dioxide emissions
27 February 2023New award from the U.S. Dept. of Energy will help researchers develop green technology to capture carbon dioxide emissions from power plants. https://www.eurekalert.org/news-releases/980926
-
 Environmental initiatives
Environmental initiativesCelebrate st. patrick's day by planting tress in ireland
27 February 2023When you purchase your limited edition St. Patrick's Day reforestation tee, you are also helping to support reforestation in Ireland, where we are planting 200,000 trees in 32 counties across Ireland to restore habitat for biodiversity and engage local communities in tree planting. https://onetreeplanted.org/blogs/stories/plant-trees-st-patricks-day?utm_medium=pdmr&utm_source=meta&utm_campaign=st-patricks-day&utm_content=image&utm_term=stories
-
 Environmental initiatives
Environmental initiativesChevron Aims to Shrink the Carbon Footprint of Its LNG Fleet
27 February 2023Chevron's shipping arm has set out to reduce the carbon intensity of its liquefied natural gas (LNG) fleet operations. https://www.marinelink.com/news/chevron-aims-shrink-carbon-footprint-lng-503217
-
 Environmental initiatives
Environmental initiativesU.S. Environmental Protection Agency find say power plant emissions continue to fall
27 February 2023The U.S. Environmental Protection Agency (EPA) have released the findings of its annual report into emissions from power plants, saying that they reflect the long-standing trend of decreasing emissions https://airqualitynews.com/2023/02/27/u-s-environmental-protection-agency-find-say-power-plant-emissions-continue-to-fall/
-
 Environmental initiatives
Environmental initiativesRoadmap for reducing infrastructure carbon emissions released
27 February 2023The New South Wales Government has released its Decarbonising Infrastructure Delivery Roadmap – a plan to reduce carbon emissions from infrastructure projects in order to save money, time, and help save the planet. https://infrastructuremagazine.com.au/2023/02/28/roadmap-for-reducing-infrastructure-carbon-emissions-released/
-
 Environmental initiatives
Environmental initiativesTowards Telecom's Net Zero Goal
27 February 2023The telecommunications industry has a significant impact on the environment due to its high energy consumption, which is estimated to be around 1.5-2% of global electricity. https://www.thefastmode.com/expert-opinion/30687-towards-telecoms-net-zero-goal
-
 Lifestyle
LifestyleCanadian Family wins life-changing $50,000 prize by reducing household carbon emissions
27 February 2023Can Canadians really make a difference by cutting their household carbon emissions? Five families were challenged to cut their carbon and share their experiences, with one family taking home a grand prize of $50,000 to continue their quest to live net zero. https://www.newswire.ca/news-releases/canadian-family-wins-life-changing-50-000-prize-by-reducing-household-carbon-emissions-802495241.html
-
 Companies
CompaniesSEVEN SPRING offers 100% compostable and environmentally friendly tea bags
24 February 2023Established in 2020, SEVEN SPRING is an Indian tea brand made of sheer grit, passion, and vision to revive ancient Indian goodness and natural purity. https://www.foodtechbiz.com/opinion/seven-spring-offers-100-compostable-and-environmentally-friendly-tea-bags
